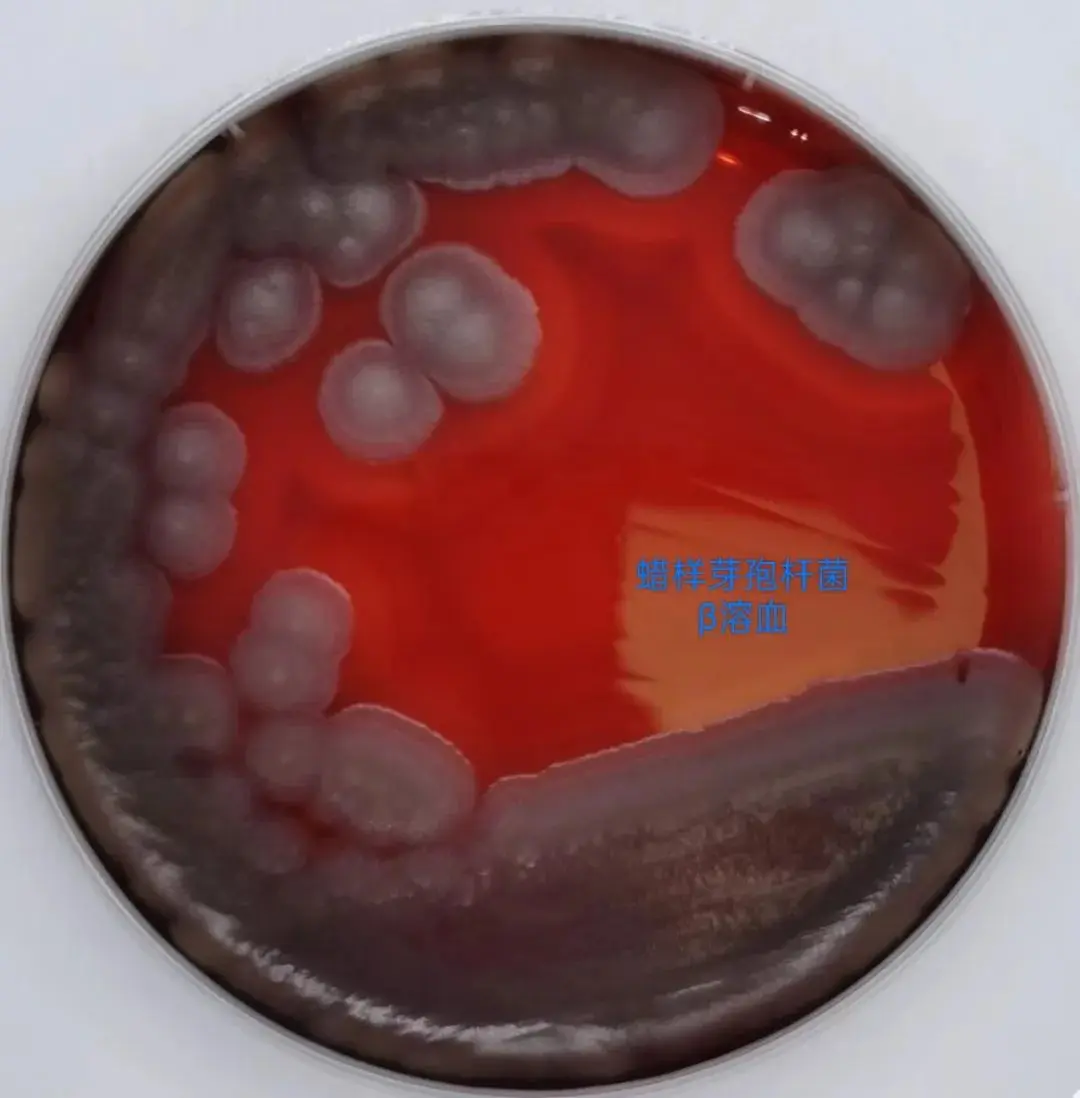
平板计数法

平板计数菌落总数能不能精确反映细菌的真实数量?
发布时间:2025-02-13 浏览次数:1641
菌落形成单位(Colony-Forming Unit, CFU)是用于评估微生物数量的一种标准单位,通常用于细菌、酵母菌等微生物的计数。CFU表示在特定条件下,一个微生物细胞或微生物群体能够在固体培养基上形成可见的菌落的数量。这一指标在微生物学研究、食品卫生检测、环境监测等领域具有重要意义。
CFU的计数方法包括传统的平板计数法,以及利用数字图像处理技术进行半自动计数的方法。平板计数法是通过将样品稀释后涂布在固体培养基上,然后在适宜的条件下培养,最后统计形成的菌落数量。这种方法虽然准确,但耗时较长且需要较多的人工操作。而数字图像处理技术则通过自动识别和计数培养基上的菌落,提高了计数效率和准确性。
CFU的计数结果受多种因素影响,包括样品的稀释度、培养基的类型、培养条件等。例如,在研究牛支原体的培养效果时,通过倾注培养法和颜色变化单位(CCU)法对CFU进行计数,结果显示在不同时间点CFU的数量变化显著。此外,CFU计数还可能受到样品中微生物种类的影响,不同微生物在相同条件下形成的菌落数量可能有所不同。
为什么平板上的菌落数不等于细菌总数?
1、培养条件限制:平板计数法是在特定的培养条件下进行的,例如需氧条件、特定的温度和培养时间等。 这些条件可能无法满足所有细菌的生长需求,特别是厌氧菌、微需氧菌以及具有特殊营养需求的细菌可能无法在该环境中生长,因此无法被计数。
2、菌落形成单位(CFU)与活菌数的区别:菌落总数是指在培养基上能够形成可见菌落的细菌数量,而这些菌落是由单个细菌或少量细菌形成的。 然而,并非所有细菌在培养基上都能形成独立的菌落,有些细菌可能因为密度过高而形成一个大的菌落,或者两个或多个细菌连在一起形成一个菌落。 因此,统计的菌落数往往少于实际的活菌数。
3、片状生长和蔓延生长的影响:当样品中的细菌浓度过高时,可能会出现菌落蔓延成片状或链状的情况,这种情况下,一个菌落可能包含多个细菌,导致计数结果偏低。 因此,对于有片状生长的平板,通常需要舍弃或采用其他方法来计算菌落数。
4、检测方法的局限性:平板计数法只能检测在特定培养条件下能够生长的细菌种类,而不能区分不同种类的细菌。 这意味着即使某些细菌在实验条件下无法生长,但它们仍然存在于样品中,从而导致菌落总数低于实际细菌总数。
5、操作误差:实验操作中的误差也是影响菌落数与细菌总数不一致的重要因素。例如,样品稀释不当、涂布不均匀、培养时间过长或过短等都会对最终的菌落数产生影响。在某些情况下,如果培养时间过长,菌落可能会发生融合,导致计数结果偏高;而培养时间过短,则可能导致部分细菌未能形成可见的菌落,计数结果偏低。
文章来源:环凯转载于“ 检验世界”公众号;原标题:“平板计数菌落总数能不能精确反映细菌的真实数量?”;作者~小石学检验。
转载声明:本文为转载发布,仅为分享学习目的。对转载有异议和删稿要求的原著方,可联络站点客服删除。







